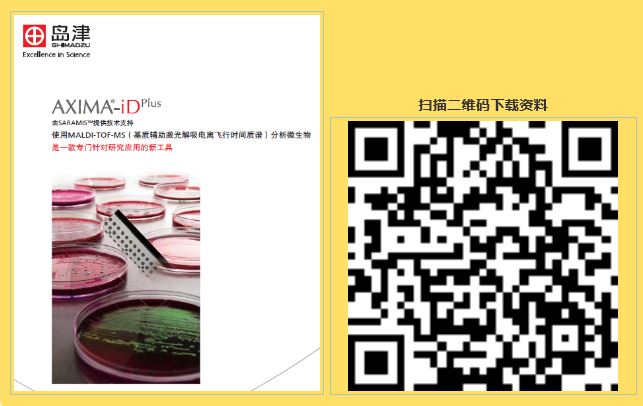
1622164176526517.jpg 7.JPG

發(fā)布時間:2021-05-28 閱讀次數(shù):934次
2021年5月25日,島津在中國農(nóng)業(yè)大學(xué)動物醫(yī)學(xué)院順利舉辦了MALDI-TOF workshop。中國農(nóng)業(yè)大學(xué)動物醫(yī)學(xué)院目前配備有兩套島津MALDI-TOF設(shè)備,運轉(zhuǎn)和應(yīng)用狀況良好;同時中國農(nóng)大獸藥安全評價中心作為島津的合作實驗室,雙方在設(shè)備的使用、維護和先進科研領(lǐng)域的應(yīng)用等方向,形成了緊密的合作并收獲良好效果。此次應(yīng)用交流會聚焦于微生物鑒定應(yīng)用領(lǐng)域,雙方就實際應(yīng)用案例、應(yīng)用場景、設(shè)備操作及數(shù)據(jù)庫使用等諸多主題進行深入探討。


中國農(nóng)業(yè)大學(xué)動物醫(yī)學(xué)院朱奎教授肯定了島津MALDI-TOF在科研應(yīng)用中所發(fā)揮的重要作用,對于雙方的良好合作給予了高度評價;同時也對未來雙方在科研領(lǐng)域的更多前沿合作提出了期待。

來自島津營業(yè)部業(yè)務(wù)擔當宋爽介紹了本次workshop日程以及主講嘉賓。

中國農(nóng)業(yè)大學(xué)博士生李倩分享島津MALDI-TOF在動物源微生物研究中的應(yīng)用。

島津分析中心工程師黃成才介紹MALDI-TOF原理及在微生物鑒定中的應(yīng)用。

島津分析中心工程師黃成才對參會人員分組進行實驗講解及儀器操作培訓(xùn)。
微生物鑒定綜合樣本下載